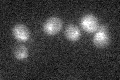
YOR357C
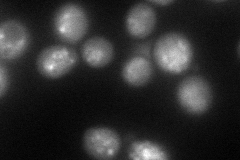
YOR357C
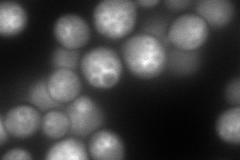
YOR357C
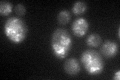
YOR357C
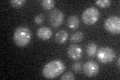
YOR357C

View description
Sorting nexin required to maintain late-Golgi resident enzymes in their proper location by recycling molecules from the prevacuolar compartment; contains a PX domain and sequence similarity to human Snx3p
Localization:
Intensity:
Fold change:
Significance:
-
C’ GFP library in SD
vacuole membrane27.84 -
N' NOP1pr-GFP in SD
vacuole membrane149.309 -
N' TEF2pr-mCherry in SD
vacuole membrane189.914 -
N' NATIVEpr-GFP in SD

vacuole35.5056 -
N' TEF2pr-VC and Cyto-VN in SD

vacuole membrane58.4385 -
C’ GFP library in SD+DTT
vacuole membraneN/AN/ANo -
C’ GFP library in SD+H2O2

vacuole membraneN/AN/ANo -
C’ GFP library in Starvation Media
vacuole membraneN/AN/AYes -
C’ GFP library on the background of Pup2-DaMP

vacuole membrane -
C’ GFP library on the background of CCT mutant

vacuole membraneN/AN/ANo
